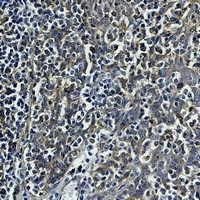
TUBB Antibody in Immunohistochemistry (Paraffin) (IHC (P))

Search
Abnova
TUBB Recombinant Rabbit Monoclonal Antibody
{{$productOrderCtrl.translations['antibody.pdp.commerceCard.promotion.promotions']}}
{{$productOrderCtrl.translations['antibody.pdp.commerceCard.promotion.viewpromo']}}
{{$productOrderCtrl.translations['antibody.pdp.commerceCard.promotion.promocode']}}: {{promo.promoCode}} {{promo.promoTitle}} {{promo.promoDescription}}. {{$productOrderCtrl.translations['antibody.pdp.commerceCard.promotion.learnmore']}}
图: 1 / 2
TUBB Antibody (RAB02475) in IHC (P)


Please note: We are reviewing Western blot images included in the antibody testing data in our catalog, including those provided by third parties. Unless expressly labeled or annotated as “raw-unedited”, Western blot images included in the antibody testing data in our catalog may have been edited, optimized or otherwise adjusted for presentation.
产品信息
RAB02475
种属反应
宿主/亚型
Expression System
分类
类型
偶联物
形式
纯化类型
保存液
内含物
保存条件
运输条件
靶标信息
Microtubules, the major cytoskeletal elements found in all eukaryotic cells, consist of Tublin, which is a dimer of two 55kDa subunits: alpha and Beta. Microtubules play key roles in chromosome segregation in mitosis, intracellular transport, ciliary and flagellar bending, and structural support of the cytoskeleton. This antibody does not cause the 10-nm filaments to collapse into large lateral aggregates collecting in the cell periphery or tight juxtanuclear caps. It does not block microtubule assembly. Ab-3 does not inhibit polymerization or depolymerization of platelet tubulin in vitro. It blocks (by 70-80%) the ability of tubulin dimers (with GppNHp bound) to promote a stable inhibition of adenylyl cyclase.
仅用于科研。不用于诊断过程。未经明确授权不得转售。
篇参考文献 (0)
生物信息学
蛋白别名: tbb5; tubulin beta; Tubulin beta chain; Tubulin beta-5 chain
基因别名: AA408537; AI596182; B130022C14Rik; M(beta)5; OK/SW-cl.56; TUBB; TUBB5
UniProt ID: (Mouse) P99024, (Rat) P69897
Entrez Gene ID: (Mouse) 22154, (Rat) 29214